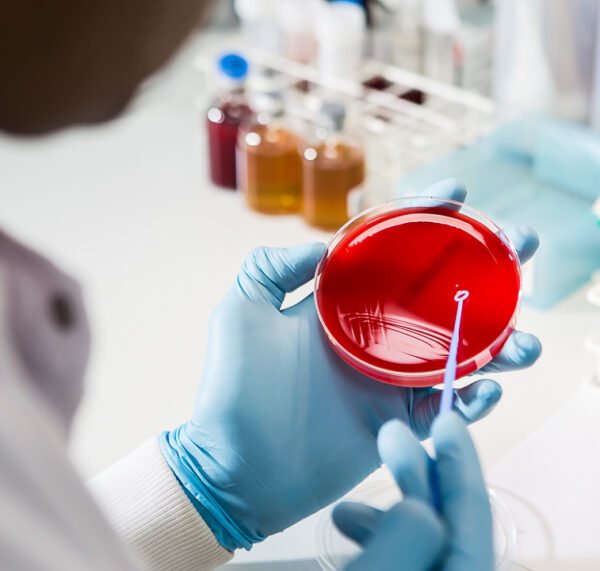

In-House Diagnostic & Testing Lab
At Pets Planet India, we offer state-of-the-art in-house diagnostic and testing lab services to ensure fast, accurate, and reliable results for your pet’s health. Early diagnosis plays a critical role in effective treatment, and our advanced lab facilities help us detect and monitor a wide range of medical conditions in real time.
Our Testing Services Include:
-
Blood Tests: Complete Blood Count (CBC), liver & kidney function tests, sugar levels, etc.
-
Urine & Fecal Tests: Detection of infections, parasites, and urinary health issues.
-
Skin & Allergy Tests: Diagnosis of skin infections, allergies, and fungal conditions.
-
Microscopy & Cytology: Cell analysis for tumors, infections, and abnormal growths.
-
Rapid Tests: On-the-spot tests for diseases like parvovirus, distemper, and tick fever.
With quick turnaround times and precise reporting, our lab supports accurate diagnoses and helps us monitor treatment progress closely. At Pets Planet India, your pet’s health is in safe and scientific hands.

